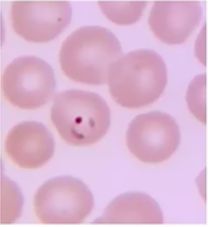
Flashcard 20 image

Following is an egg of: _____

The following organism is _____
Following is an egg of: _____

The given image is the trophozoite form of the _____.

The following organism is _____
Following are the eggs of _____

Kinyoun-positive oocysts with large sizes(25 μm), as in the image are formed by _____.

The egg in the image is of _____ and it is treated by praziquantel (5–10 mg/kg once)

Following is an egg of: _____

Which form of Plasmodium spp. is seen here? _____
Classification of Parasites
Flashcards
Intestinal Protozoa
Flashcards
Blood and Tissue Protozoa
Flashcards
Malaria Parasites
Flashcards
Leishmaniasis
Flashcards
Intestinal Helminths: Nematodes
Flashcards
Tissue Nematodes
Flashcards
Trematodes
Flashcards
Cestodes
Flashcards
Ectoparasites
Flashcards
Antiparasitic Drugs
Flashcards
Laboratory Diagnosis of Parasitic Infections
Flashcards
Get full access to all flashcards, spaced repetition, and progress tracking.
Start For Free